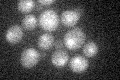
YER063W
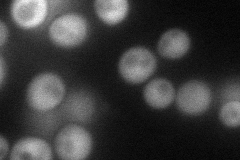
YER063W
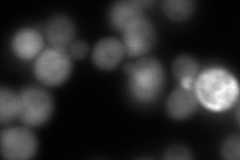
YER063W
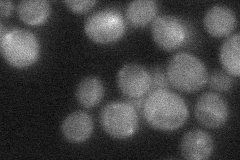
YER063W
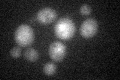
YER063W

View description
Conserved nuclear RNA-binding protein; specifically binds to transcribed chromatin in a THO- and RNA-dependent manner, genetically interacts with shuttling hnRNP NAB2; overproduction suppresses transcriptional defect caused by hpr1 mutation
Localization:
Intensity:
Fold change:
Significance:
-
C’ GFP library in SD
nucleus19.14 -
N' NOP1pr-GFP in SD
cytosol76.4855 -
N' TEF2pr-mCherry in SD
cytosol7.93896 -
N' NATIVEpr-GFP in SD
cytosol29.1508 -
N' TEF2pr-VC and Cyto-VN in SD

cytosol27.87 -
C’ GFP library in SD+DTT
nucleus19.711.02No -
C’ GFP library in SD+H2O2

nucleus14.820.77No -
C’ GFP library in Starvation Media

nucleus17.60.91No -
C’ GFP library on the background of Pup2-DaMP

nucleus -
C’ GFP library on the background of CCT mutant

nucleus19.2321.00418No
